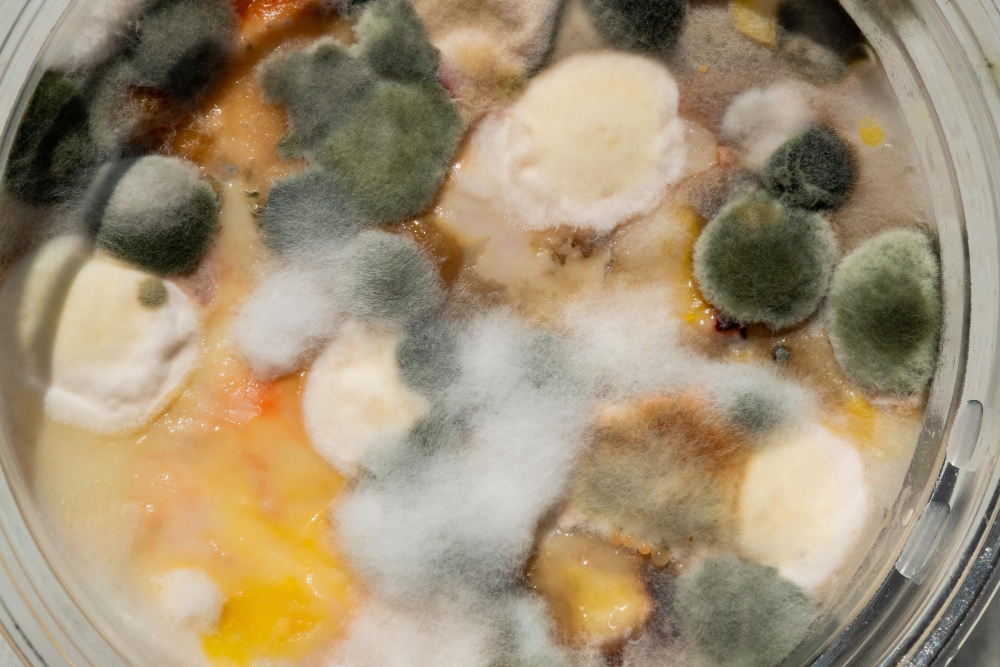
Ensuring Food Safety: Tackling Microbial Threats in the Food and Beverage Industry advanced food testing methods, AI in food microbiology, antimicrobial resistance food safety, climate change food safety impact, food safety regulations and compliance, Food safety technology, food supply chain safety, foodborne illness prevention, microbial contamination detection, sustainable food safety practices Food and Beverage Business Ensuring Food Safety,Tackling Microbial Threats,food safety technology,microbial contamination detection,foodborne illness prevention,AI in food microbiology,advanced food testing methods,food supply chain safety,sustainable food safety practices,climate change food safety impact,antimicrobial resistance food safety,food safety regulations and compliance

The food and beverage industry operates within a complex landscape where product safety is paramount. Microbial contamination poses a persistent threat, capable of occurring at any stage from production to consumption. To combat this, the industry is increasingly adopting advanced microbiological testing methods and innovative technologies to detect, mitigate, and ultimately prevent these hazards.
Maintaining stringent hygiene throughout the production process is the first line of defense. From raw ingredient arrival to packaging and distribution, sanitized equipment, meticulous hand hygiene, and sterile workspaces are essential. Implementing robust handling protocols, such as preventing cross-contamination by segregating raw and ready-to-eat products and ensuring thorough cleaning of machinery and surfaces between tasks, creates a strong barrier against potential contaminants.

Despite these preventative measures, lapses can occur, leading to outbreaks of foodborne illnesses caused by pathogens like Salmonella, E. coli, and Listeria. Such incidents not only endanger public health, particularly vulnerable populations like the elderly, pregnant women, children, and immunocompromised individuals, but also severely damage a company’s reputation.
To enhance detection and prevention, the industry is embracing advanced molecular techniques. Polymerase chain reaction (PCR) and next-generation sequencing (NGS) enable rapid and accurate identification of specific pathogens by analyzing their genetic material, facilitating quicker responses to contamination and minimizing the risk of widespread outbreaks. Nanotechnology is also being explored for its potential in pathogen detection and elimination, with antimicrobial nanomaterials being developed for food packaging to extend shelf life and prevent contamination.
Remote sensing technologies, including hyperspectral imaging and spectroscopy, offer non-invasive, real-time monitoring of food surfaces for microbial contamination without compromising product integrity. Furthermore, artificial intelligence (AI) and machine learning (ML) are being leveraged to analyze vast datasets, improving risk assessment and decision-making. Advancements in predictive microbiology models, driven by AI/ML, provide a deeper understanding of microbial growth and behavior under various conditions, leading to more effective prevention strategies.
AI-powered image analysis systems, for example, can rapidly and accurately examine microscopic images of food samples to identify potential contaminants, automating a process that is traditionally time-consuming and labor-intensive. Predictive modeling, also powered by AI, analyzes historical contamination records, environmental factors, and production processes to forecast potential outbreaks and pinpoint vulnerabilities within the supply chain, enabling proactive interventions. Real-time monitoring of critical control points is further enhanced through AI-enabled sensors and Internet of Things (IoT) devices, continuously monitoring factors like temperature and humidity and promptly alerting personnel to deviations that could pose contamination risks.
The integration of AI into food microbiology testing offers several key benefits: expedited testing procedures for rapid contaminant identification and response; enhanced accuracy in pathogen detection, minimizing false positives and negatives; increased sensitivity in contamination detection by discerning subtle patterns and anomalies; and cost reductions through automation and optimized resource utilization.
However, implementing AI in food safety presents challenges. The effectiveness of AI models depends on the quality and comprehensiveness of training data; inadequate or biased data can lead to inaccurate results. Robust data privacy and security measures are essential to protect sensitive information. Ethical considerations, such as potential workforce displacement and the need for responsible AI development and deployment, must also be addressed.

Rapid pathogen identification is crucial for effective product recalls in the event of contamination. High-throughput genome sequencing allows for precise outbreak tracking, enabling targeted recalls and minimizing public health risks by linking pathogens found in contaminated food with those in affected individuals.
Beyond detection, the industry is also focusing on sustainable practices. For example, initiatives to reuse personal protective equipment (PPE) through innovative washing systems, like those employing ozone, are being implemented to reduce waste and environmental impact.
The globalization of the food supply chain introduces further complexities, as products sourced from diverse regions may be subject to varying safety standards and environmental conditions. This necessitates robust international food safety standards and collaboration among regulatory agencies to ensure consistent safety measures across borders.
Climate change further complicates food safety efforts, as shifts in temperature, humidity, and weather patterns can influence the prevalence and behavior of foodborne pathogens. Warmer temperatures, for instance, can promote the growth of certain bacteria. Antimicrobial resistance (AMR) is another growing concern, requiring new strategies to combat pathogens that have evolved resistance to traditional treatments.
To address these multifaceted challenges, the industry is investing in research and development of new antimicrobial agents and alternative preservation methods, while also emphasizing consumer education on safe food handling practices.
In conclusion, ensuring food safety in today’s interconnected world requires a comprehensive approach encompassing rigorous hygiene, advanced detection technologies, sustainable initiatives, global collaboration, and proactive adaptation to emerging threats like climate change and AMR. By continuously improving safety protocols and embracing innovation, the food and beverage industry can effectively protect public health and maintain consumer trust.

